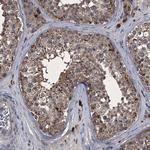
MAPKAP1 Antibody in Immunohistochemistry (Paraffin) (IHC (P))

Search
Invitrogen
MAPKAP1 Polyclonal Antibody
{{$productOrderCtrl.translations['antibody.pdp.commerceCard.promotion.promotions']}}
{{$productOrderCtrl.translations['antibody.pdp.commerceCard.promotion.viewpromo']}}
{{$productOrderCtrl.translations['antibody.pdp.commerceCard.promotion.promocode']}}: {{promo.promoCode}} {{promo.promoTitle}} {{promo.promoDescription}}. {{$productOrderCtrl.translations['antibody.pdp.commerceCard.promotion.learnmore']}}

Please note: We are reviewing Western blot images included in the antibody testing data in our catalog, including those provided by third parties. Unless expressly labeled or annotated as “raw-unedited”, Western blot images included in the antibody testing data in our catalog may have been edited, optimized or otherwise adjusted for presentation.
产品信息
PA5-83061
种属反应
宿主/亚型
分类
类型
抗原
偶联物
形式
浓度
规格
纯化类型
保存液
内含物
保存条件
运输条件
RRID
产品详细信息
Immunogen sequence: ATVQDMLSSH HYKSFKVSMI HRLRFTTDVQ LGISGDKVEI DPVTNQKAST KFWIKQKPIS IDSDLLCACD LAEEKSPSHA IFKLTYLSNH DYKHLYFESD AATVNEIVLK VNYILESRAS TARADYFAQK QRKLNRRTSF SFQKEKKSGQ
Highest antigen sequence indentity to the following orthologs: Rat - 97%, Mouse - 97%.
靶标信息
Sin1 was initially identified as the human homolog of S. pombe SIN1. Recent evidence has shown that it identical to Mip1, a protein that interacts with MEKK2, a member of the mitogen-activated protein kinase (MAPK) intracellular signaling network. MAPKAP1 is thought to prevent MEKK2 activation and dimerization by forming a complex with the inactive and non-phosphorylated MEKK2, thereby blocking the JNK1/2, ERK1/2, p38 and ERK5 MAPKs. MAPKAP1 has also been shown to play a role in the TOR signaling process, a pathway that is involved in controlling cell growth and proliferation in response to environmental cues such as nutrients, growth factors and hormones. Experiments showed that MAPKAP1 helped to maintain the TOR/rictor assembly but not the TOR/RAPTOR complex, which allowed specific phosphorylation of Akt, a kinase that is believed to couple the growth factor-PI3K signaling pathway to the nutrient-regulated TOR signaling pathway. Multiple alternatively spliced isoforms of MAPKAP1 have been identified.
仅用于科研。不用于诊断过程。未经明确授权不得转售。
篇参考文献 (0)
生物信息学
蛋白别名: MGC2745; MIP1SIN1SIN1b; Mitogen-activated protein kinase 2-associated protein 1; RP11-269P11.1; SAPK-interacting protein 1; Stress-activated map kinase-interacting protein 1; Target of rapamycin complex 2 subunit MAPKAP1; TORC2 subunit MAPKAP1
基因别名: MAPKAP1; MIP1; SIN1
Entrez Gene ID: (Human) 79109




